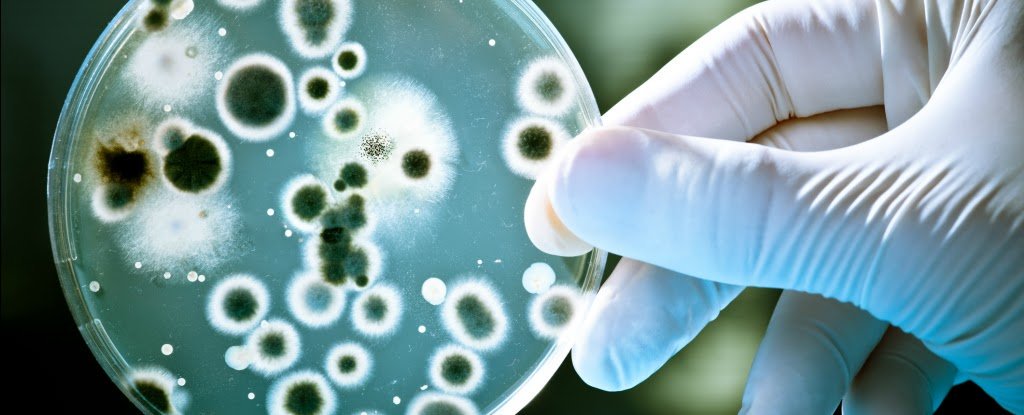

Antibiyotiğe karşı dayanıklılık gösteren ve basit hastalıklardan ötürü binlerce kişinin ölümüne neden olabilen bakteri yayılmaya devam ediyor. “Kabus bakteri” olarak isimlendirilen bakterinin geçen seneye kıyasla 200 kat fazla kişiye yayıldığı tespit edildi.
Bilim insanları tarafından “kabus bakteri” olarak isimlendirilen ve antibiyotiğe karşı direnç geliştiren bakteri türü yayılmaya devam ediyor. Geçen sene birçok kişinin ölümüne neden olmasıyla birlikte bilim insanlarını harekete geçiren bu zorlu bakteri, antibiyotik kullanımından etkilenmemesinden ötürü en basit hastalıkların bile binlerce sağlıklı ve genç kişiyi öldürmesine neden olabiliyor.
Bakterinin yayılmasını durdurabilmek adına gereksiz ve düzensiz antibiyotik kullanımının önüne geçilmeye çalışılıyor. Kişinin hasta olmasına neden olan bakteri, antibiyotiğin yanlış veya gereksiz şekilde kullanılmasıyla bu güçlü ilaca karşı bağışıklık kazanabiliyor ve yalnızca hastanın değil, çevresindeki herkesin hayatını tehlikeye atıyor. ABD’de yapılan araştırmalar, antibiyotiğe karşı bağışıklığı olan bakterinin rol oynadığı 2 milyon vakanın 23.000 kişinin ölümüyle sonuçlandığını ortaya koydu.
Bilim insanları ve yetkililer, geçtiğimiz seneye kıyasla 200 kat daha fazla kişide bu bakteriye rastlanıldığını dile getirdi. Çoğunlukla hastalıklı olarak seyahat eden bireylerin bakteriyi taşıdığı biliniyor. Avrupa da dahil olmak üzere ABD’de bulunan kabus bakteriye birçok kıtada rastlanıldı.

Yorum bırakın